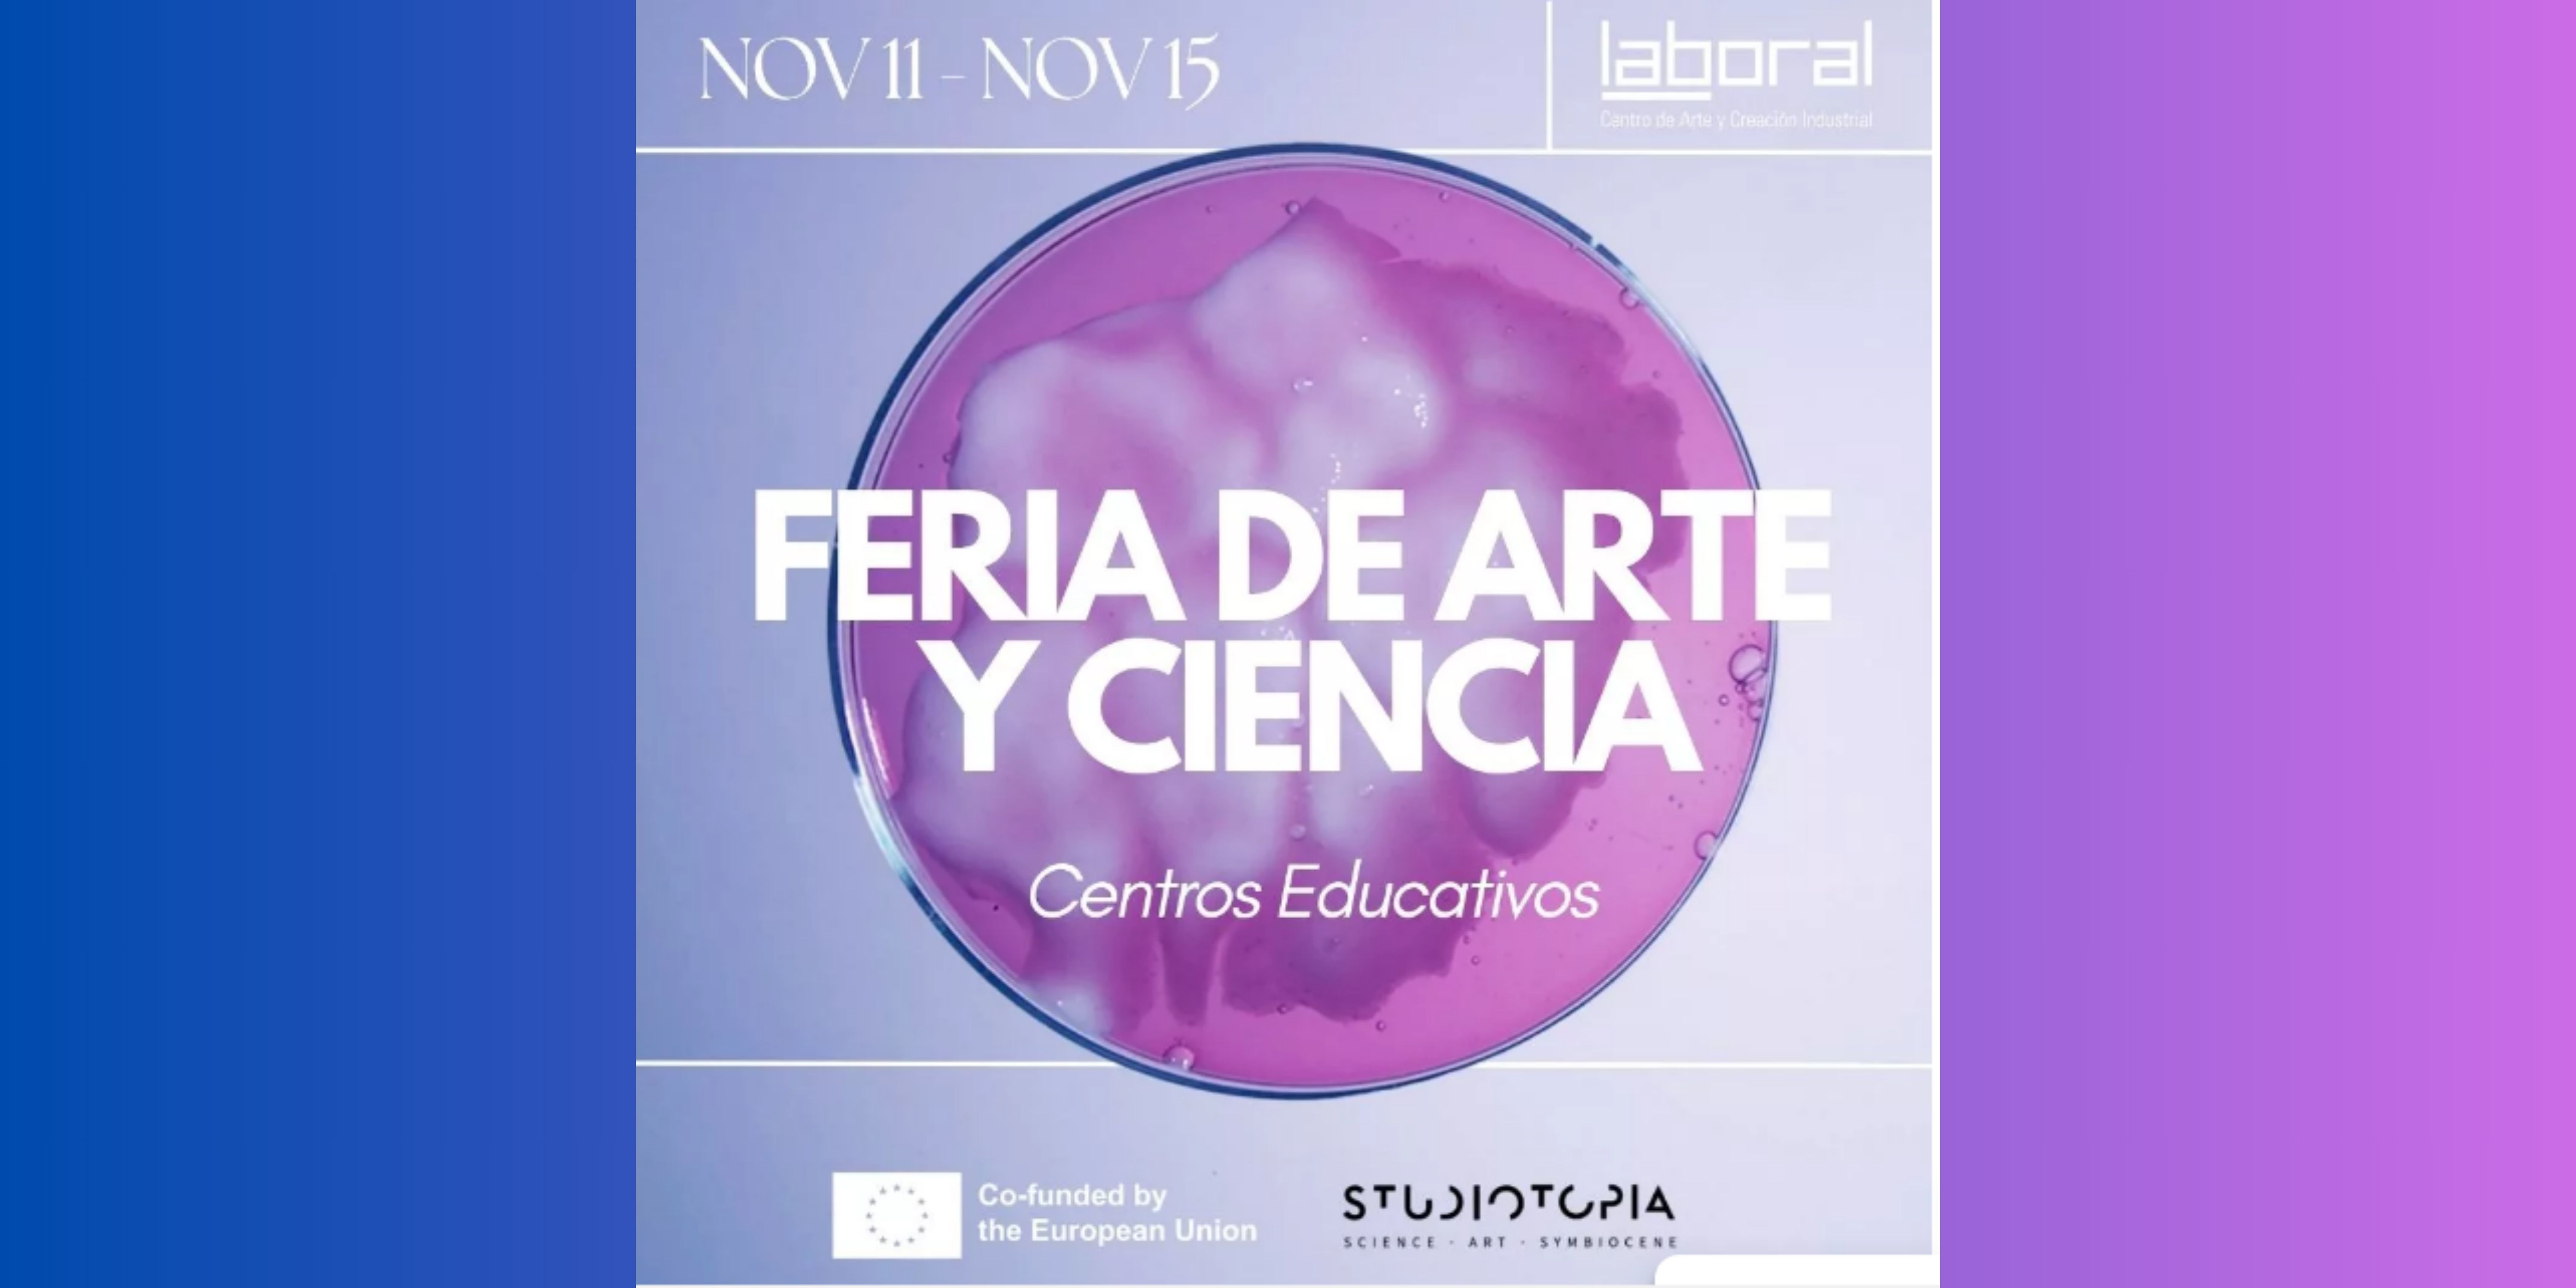

Feria de Arte y Ciencia: talleres para jóvenes de 14 a 16 años
La Feria de Arte y Ciencia es una experiencia única que invita a aprender haciendo, a explorar sin miedo y a descubrir qué sucede cuando combinamos la creatividad del arte con la curiosidad de la ciencia. Un espacio para experimentar, crear y soñar con nuevas posibilidades.
¿A quién va dirigido?
A estudiantes de 3º y 4º de ESO que se convertirán en investigadores y artistas participando en talleres que despiertan la imaginación y el pensamiento crítico.
¿Cuándo?
Del 11 al 15 de noviembre
La Feria de Arte y Ciencia es un programa desarrollado por LABoral Centro de Arte junto a GRIGRI, enmarcado en el proyecto europeo Studiotopia, una iniciativa en la que participan 11 organizaciones culturales y científicas de toda Europa, entre ellas LABoral. El objetivo del proyecto es explorar la intersección entre arte y ciencia promoviendo el diálogo entre ambas disciplinas para abordar los principales desafíos globales de nuestra sociedad actual
Las actividades se realizan siempre previa reserva, poniéndose en contacto con el área de educación de LABoral Centro de Arte a través de los siguientes medios, correo electrónico: educacion@laboralcentrodearte.org, o teléfono: 985 185 577
Para más información visita www.laboralcentrodearte.org